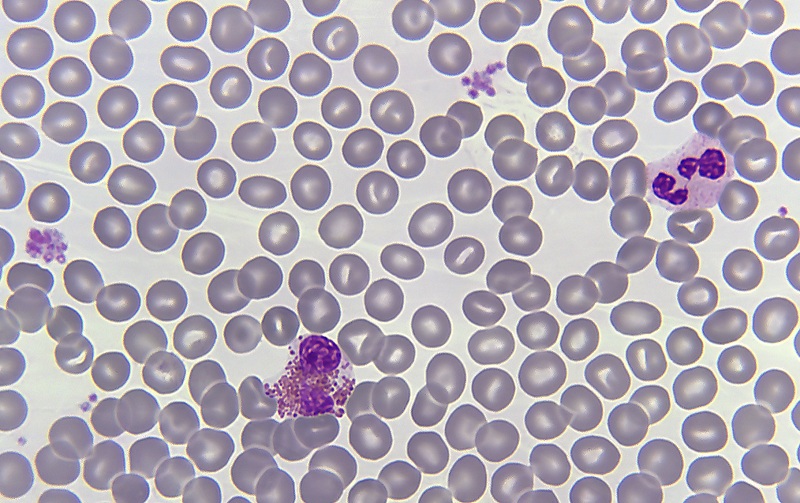

Omdat de prostaat bij veel mannen na hun 30e wat groter worden, kunnen er bij sommige mannen plasklachten optreden. Een vergrote prostaat of plasklachten betekent niet dat iemand prostaatkanker heeft of krijgt. Signalen van, meestal onschuldige, prostaatproblemen zijn:. Bloed in de urine of sperma;. Een vergrote prostaat kan leiden tot plasklachten doordat de plasbuis gedeeltelijk wordt dicht gedrukt. Daarnaast zorgt een vergrote prostaat ook voor prikkeling van de blaas.. Plasklachten, erectieklachten, bloed in urine, troebele urine, of bloed in sperma. Tevens zullen de uitslagen worden beoordeeld door een klinisch chemicus, waarmee u.

Bloed in je urine, wat zijn de oorzaken? Dokter.nl

An enlarged prostate gland and incontinence Harvard Health

Vergrote prostaat operatie Symptomen en behandeling

Vergrote prostaat en erectieproblemen Hoe te handelen?

Wat zijn symptomen van prostaatkanker? YouTube

9 Symptomen Van Prostaatvergroting Human Nature

Vergrote prostaat Symptomen, oorzaken en behandeling

Bloed in de urine Deventer Ziekenhuis

Urine vies? Juist nuttig! Hier kun je je plas voor gebruiken RTL Nieuws
bloed in urine oorzaak DrBeckmann

Gezondheidstest voor 10 indicatoren, urineonderzoek bloed in urine... bol

Goedaardige ProstaatHyperplasia Vector Illustratie Illustration of voorstanderklier, vergroot

What Causes Blood in Urine? Blood Test Results Explained

bloed in urine oorzaak DrBeckmann

Blaasontsteking en bloed in urine (mannen) Link2Care

Vitakruid Prostaatformule Skin Clinic Damla

Bloed in de urine? Ga naar uw huisarts Urologie

Prostatitis and what you need to know Urology Specialist

Kinderneurologie.eu

Prostaattherapie zonder operatie Nederlands Dagblad
Op hogere leeftijd groeit de prostaat in volume. Deze leeftijdsgebonden toename van goedaardig prostaatweefsel wordt 'benigne prostaathypertrofie' genoemd (= B.P.H.). Het nadeel van deze volumetoename is dat de plasbuis hierdoor kan worden dichtgedrukt, wat het plassen bemoeilijkt. Een prostaatvergroting heeft niets met prostaatkanker te maken.. Prostaatklachten door een vergrote prostaat. Bij de meeste mannen wordt de prostaat na hun dertigste langzaam groter. Dit is vaak niet erg. Sommige mannen krijgen hierdoor klachten.. bloed in de urine of in het sperma; Als mannen ouder worden, komen deze klachten vaker voor. Deze klachten betekenen dus niet dat je prostaatkanker hebt.